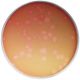
Going Un-Viral: Virus Quantification Using Plaque Assays, Manufacturer reference: 209

Cleavage of Lambda DNA with Eco RI Restriction Enzyme, Manufacturer reference: 212
ABOUT THIS PRODUCT:
DOWNLOAD SAMPLE INSTRUCTIONS

Details
Group Size:
For 10 restriction digestions and 5 gels
Time Required:
Complete in 90 minutes
Kit Includes:
Instructions, Lambda phage DNA, Concentrated Restriction Enzyme Reaction Buffer, EDVOTEK® Enzyme Grade Water, Eco RI Dryzymes™ endonuclease, DNA Standard Marker, Reconstitution Buffers, UltraSpec-Agarose™, 10X Gel Loading Solution, 50X Concentrated Electrophoresis Buffer, Practice Gel Loading Solution, FlashBlue™ DNA Stain, InstaStain™ Blue Cards, Disposable Pipets, Microtest Tubes, & Semi-log Graph Paper Template.
All You Need:
DNA Electrophoresis, Micropipettes: 5-50 µl, Water Bath, White Light Box, & Microwave or Hot Plate.
Storage:
Some Components Require Freezer Storage Upon Receipt
Replenisher:
- #212 FB - EDVO-Kit #212 Replenisher (Comp. A-G)
Resource
Quick Guides:
Safety Data Sheets:
Instructional Videos:
| Manufacturer | Edvotek Inc. |
|---|---|
| Size / Rxns Number: | No |
| Protocol & Manual | No |
| Technical Tips | No |